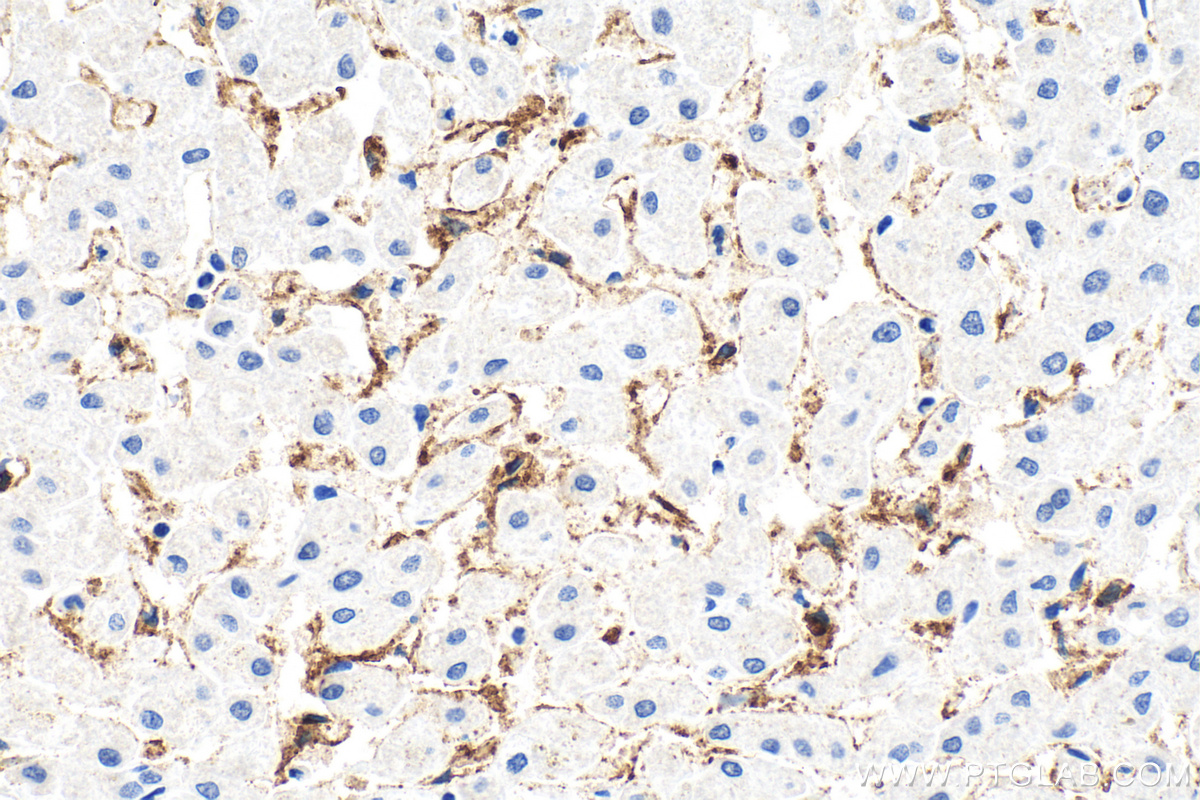
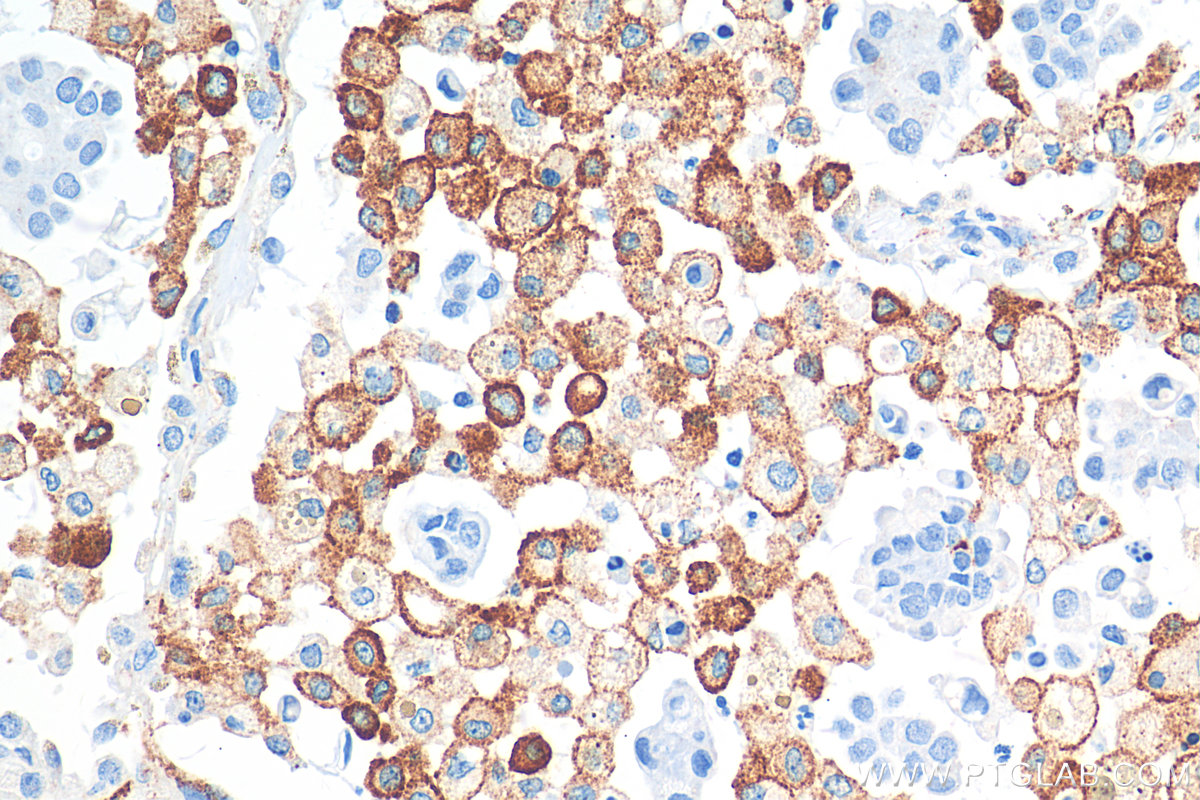

验证数据展示
经过测试的应用
| Positive WB detected in | pig liver tissue, rat liver tissue, human placenta tissue |
| Positive IHC detected in | human lung cancer tissue, human colon cancer tissue, human liver tissue, human lung tissue, human lymphoma tissue, human placenta tissue Note: suggested antigen retrieval with TE buffer pH 9.0; (*) Alternatively, antigen retrieval may be performed with citrate buffer pH 6.0 |
| Positive IF-P detected in | human placenta tissue |
| Positive IF/ICC detected in | PMA, IL-4, and IL-13 treated THP-1 cells |
推荐稀释比
| 应用 | 推荐稀释比 |
|---|---|
| Western Blot (WB) | WB : 1:5000-1:50000 |
| Immunohistochemistry (IHC) | IHC : 1:1000-1:4000 |
| Immunofluorescence (IF)-P | IF-P : 1:50-1:500 |
| Immunofluorescence (IF)/ICC | IF/ICC : 1:50-1:500 |
| It is recommended that this reagent should be titrated in each testing system to obtain optimal results. | |
| Sample-dependent, Check data in validation data gallery. | |
产品信息
81525-1-RR targets CD206 in WB, IHC, IF/ICC, IF-P, ELISA applications and shows reactivity with human, rat, pig samples.
| 经测试应用 | WB, IHC, IF/ICC, IF-P, ELISA Application Description |
| 文献引用应用 | WB, IHC, IF |
| 经测试反应性 | human, rat, pig |
| 文献引用反应性 | human, rat, pig, bovine |
| 免疫原 |
Peptide 种属同源性预测 |
| 宿主/亚型 | Rabbit / IgG |
| 抗体类别 | Recombinant |
| 产品类型 | Antibody |
| 全称 | mannose receptor, C type 1 |
| 别名 | CLEC13D, CLEC13DL, C-type lectin domain family 13 member D, C-type lectin domain family 13 member D-like, hMR |
| 计算分子量 | 166 kDa |
| 观测分子量 | 170 kDa |
| GenBank蛋白编号 | NM_002438 |
| 基因名称 | CD206 |
| Gene ID (NCBI) | 4360 |
| RRID | AB_2935558 |
| 偶联类型 | Unconjugated |
| 形式 | Liquid |
| 纯化方式 | Protein A purification |
| UNIPROT ID | P22897 |
| 储存缓冲液 | PBS with 0.02% sodium azide and 50% glycerol, pH 7.3. |
| 储存条件 | Store at -20°C. Stable for one year after shipment. Aliquoting is unnecessary for -20oC storage. |
背景介绍
CD206, also named as MMR, CLEC13D and MRC1, is a type I membrane receptor that mediates the endocytosis of glycoproteins by macrophages. CD206 has been shown to bind high-mannose structures on the surface of potentially pathogenic viruses, bacteria, and fungi so that they can be neutralized by phagocytic engulfment. CD206 is a 170 kDa transmembrane protein which contains 5 domains: an amino-terminal cysteine-rich region, a fibronectin type II repeat, a series of eight tandem lectin-like carbohydrate recognition domains (responsible for the recognition of mannose and fucose), a transmembrane domain, and an intracellular carboxy-terminal tail. It is expressed on most tissue macrophages, in vitro derived dendritic cells, lymphatic and sinusoidal endothelia.
实验方案
| Product Specific Protocols | |
|---|---|
| IF protocol for CD206 antibody 81525-1-RR | Download protocol |
| IHC protocol for CD206 antibody 81525-1-RR | Download protocol |
| WB protocol for CD206 antibody 81525-1-RR | Download protocol |
| Standard Protocols | |
|---|---|
| Click here to view our Standard Protocols |
发表文章
| Species | Application | Title |
|---|---|---|
ACS Appl Mater Interfaces Hydrogel Loaded with Peptide-Containing Nanocomplexes: Symphonic Cooperation of Photothermal Antimicrobial Nanoparticles and Prohealing Peptides for the Treatment of Infected Wounds | ||
Cell Death Discov SPON2 facilitates osteosarcoma development by inducing M2 macrophage polarization through activation of the NF-κB/VEGF signaling axis | ||
Comput Struct Biotechnol J Integrating single-cell sequencing and clinical insights to explore malignant transformation in odontogenic keratocyst | ||
Sci Rep Programmed cell death-related gene IL20RA facilitates tumor progression and remodels tumor microenvironment in thyroid cancer | ||
BMC Complement Med Ther Qingrehuoxue formula enhances anti-PD-1 immunotherapy in NSCLC by remodeling the tumor immune microenvironment via TREM2 signaling | ||
Carbohydr Polym A multifunctional metformin loaded carboxymethyl chitosan/tannic acid/manganese composite hydrogel with promising capabilities for age-related bone defect repair |